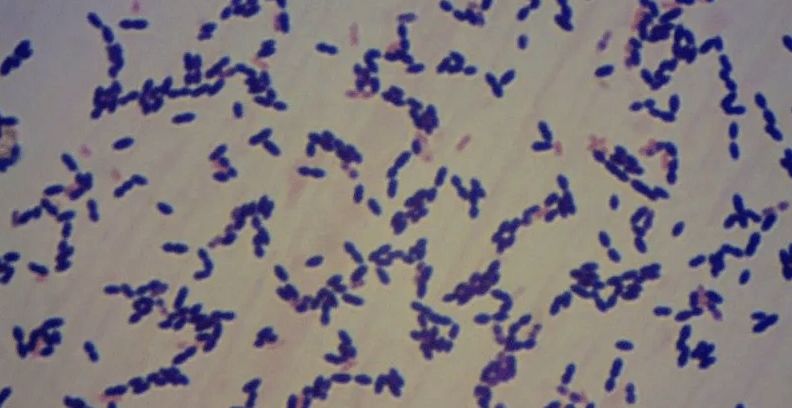

شكرا لمتابعتكم وقرائتكم خبر عن اليابان.. انتشار قياسي لبكتيريا قاتلة والحكومة تفتش عن السبب والان مع التفاصيل
الخليج 365 - الرياض- احمد حسان - يحذر خبراء الصحة في اليابان من انتشار عدوى بكتيرية نادرة وخطيرة بمعدل قياسي في أنحاء البلاد، بينما يسعى المسؤولون لتحديد السبب وراء هذه الظاهرة.
ويتزايد القلق من أن الشكل الأقسى والمميت من بكتيريا “المكورات العقدية” أو “Streptococcal” سيستمر في الانتشار، بعد رصد سلالات شديدة الخطورة والعدوى في اليابان.
ومن المتوقع أن يتجاوز عدد الإصابات في عام 2024 الأرقام القياسية المسجلة خلال العام الماضي.
وقال المعهد الوطني للأمراض المعدية في اليابان: “لا يزال هناك العديد من العوامل غير المعروفة فيما يتعلق بآليات انتشار هذه البكتيريا، ونحن لسنا في المرحلة التي يمكننا من خلالها تفسيرها”.
وسجلت الأرقام الصادرة عن المعهد الوطني للحساسية والأمراض المعدية في اليابان، 941 إصابة تم الإبلاغ عنها في العام الماضي.
لكن في الشهرين الأولين فقط من عام 2024، تم بالفعل تسجيل 378 حالة إصابة، مع تحديد حالات العدوى في جميع محافظات اليابان البالغ عددها 47، باستثناء اثنتين.
وفي حين أن كبار السن يعتبرون أكثر عرضة للخطر، فإن سلالة المجموعة “أ” من بكتيريا المكورات العقدية تؤدي إلى المزيد من الوفيات بين المرضى الذين تقل أعمارهم عن 50 عاما، وفقا للمعهد.
وذكرت صحيفة “أساهي شيمبون” المحلية، أن من بين 65 شخصا تحت سن 50 عاما تم تشخيص إصابتهم بالبكتيريا بين يوليو وديسمبر 2023، توفي حوالي الثلث، أو 21 شخصا.
عن “المكورات العقدية”
- تنتشر عدوى بكتيريا المكورات العقدية عبر الرذاذ والاتصال الجسدي، ويمكن أن تنتقل من خلال الجروح أيضا.
- يصاب به الكثيرون من دون أن يعرفوا، إذ لا تظهر عليهم أعراض.
- يمكن أن يسبب البكتيريا التهاب الحلق خاصة عند الأطفال.
- البكتيريا شديدة العدوى يمكن، في بعض الحالات، أن تسبب مضاعفات خطيرة تؤدي إلى الوفاة، خاصة عند البالغين الذين تزيد أعمارهم على 30 عاما.
- يمكن أن يعاني كبار السن أعراضا تشبه نزلات البرد، لكن في حالات نادرة يمكن أن تتفاقم الأعراض لتشمل التهاب الحلق واللوزتين والالتهاب الرئوي والتهاب السحايا.
- في الحالات الأكثر خطورة يمكن أن تؤدي العدوى إلى فشل الأعضاء.
- يعتقد بعض الخبراء أن الارتفاع السريع في الإصابات العام الماضي كان مرتبطا برفع القيود المفروضة خلال جائحة كورونا.
- تعالج البكتيريا بالمضادات الحيوية، لكن المرضى الذين يصابون بالسلالة الأكثر خطورة من المرجح أن يحتاجوا إلى مزيج من المضادات الحيوية والأدوية الأخرى، إلى جانب رعاية طبية مكثفة.
- توصي وزارة الصحة اليابانية بأن يتخذ الناس نفس احتياطات النظافة الأساسية ضد البكتيريا العقدية، التي أصبحت جزءا من الحياة اليومية أثناء جائحة كورونا.
